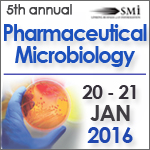

Pharmaceutical Microbiology 2016: Sterility VBNCs and Biofilms
Abbot Biologicals B.V. will be presenting on: Risk analysis and mitigation of the analysis process of sterility testing in an isolator environment
Hans Noordergraaf is a Microbiological Expert on a global level supporting different sites / products with regard to troubleshooting in production processes, regulatory filing, rapid techniques.
SMi: What do you think will be the take home message from your talk?
H.N.: Audience will benefit from the discussion on risk assessment as a key tool in prevention of failures in either analysis or processes.
In his presentation Hans Noordergraaf will focus on “false positive” sterility tests as a major concern for business continuity; a non-zero percentage Sterility test failure rate as a Regulatory Auditor topic which can be avoided; and how to use FMEA as a tool to reduce risk of “false positives” implementation of risk mitigation and on it’s influence on sterility test failure rate.
Furthermore, the Pharmaceutical Microbiology 2016 event will explore topics such as:
-Bioburden test of bulk solutions before sterilising filtration: Current practices and expectations (GSK Manufacturing S.p.A.)
- Controlling and monitoring contamination in water for pharmaceutical use (WPU) (Sanofi Pharma)
- The viable but non-cultivable (VBNC) state of pathogens: A myth or reality? (Dyson Technology)
- VBNC – How Culturable is Culturable? Detection, Non-Detection and all Points In-Between (IDEXX Laboratories)
The event will feature two exclusive half-day pre-conference workshops held on the 19th January 2016:
A) Spectrometric and Optical Technologies for Microbial Contamination Control (led by Battelle)
B) Endotoxin Testing: Hot Topics and New Methods in the European Pharmacopoeia (led by Hyglos GmbH)
Key speakers and experts include:
•Oliver Chancel, Sterility and Aseptic Process Assurance Expert, Merial Sas
•Francesco Boschi, Microbiological Services Manager, GSK Manufacturing S.p.A
•Salomé Gião, Research Scientist, Dyson Technology Ltd
•Thierry Bonnevay, Microbiology Platform Head QC Development, Sanofi Pasteur
•Adrianne Klijn, Group Leader Microbiological and Molecular Analytics, Nestle Research Center
•Sabina Lancaster, Senior Manager, Sterility Assurance, Global, QA, GSK
•James Drinkwater, Chairman, PHSS
•Tim Eaton, Sterile Manufacturing Specialist, AstraZeneca
For full speaker outline please visit: www.pharma-microbiology.com/ein
Confirmed Sponsors for 2016 – Hyglos, Lonza, Merck Millipore, IDEXX Laboratories, Mettler Toledo
To register please contact Matthew Apps: +44 (0) 207 827 1093/ mapps@smi-online.co.uk
For sponsorship enquiries please contact Alia Malick: +44(0)2078276748/ amalick@smi-online.co.uk
-------------------------- END --------------------------
About SMi Group:
Established since 1993, the SMi Group is a global event-production company that specializes in Business-to-Business Conferences, Workshops, Masterclasses and online Communities. We create and deliver events in the Defence, Security, Energy, Utilities, Finance and Pharmaceutical industries. We pride ourselves on having access to the world’s most forward thinking opinion leaders and visionaries, allowing us to bring our communities together to Learn, Engage, Share and Network. More information can be found at http://www.smi-online.co.uk
Anna Serazetdinova
SMi Group Ltd
+44 (0)20 7827 6180
email us here
Legal Disclaimer:
EIN Presswire provides this news content "as is" without warranty of any kind. We do not accept any responsibility or liability for the accuracy, content, images, videos, licenses, completeness, legality, or reliability of the information contained in this article. If you have any complaints or copyright issues related to this article, kindly contact the author above.